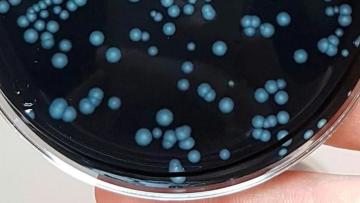
Foco de surto de ‘legionella’ em Caminha que causou um morto ficou por identificar

R. Foco de surto de ‘legionella’ em Caminha que causou um morto ficou por identificar
Segundo delegado de Saúde do Alto Minho
21 maio 2024
Etiqueta: legionella
Segundo delegado de Saúde do Alto Minho
21 maio 2024
A investigação visa apurar se os 17 casos identificados estão relacionados.
22 novembro 2023

Nove pessoas estão infetadas com ‘legionella’ nos municípios de A Guarda e O Rosal, na Galiza, Espanha, e a direção geral de Saúde Pública está a investigar a origem do surto, esta segunda-feira.
20 novembro 2023

O delegado de Saúde do Alto Minho diz que a população “pode fazer a sua vida normal”.
17 novembro 2023

A ULSAM refere que os seis doentes internados apresentam um quadro clínico estável.
16 novembro 2023

O delegado de Saúde do Alto Minho recusa, no entanto, motivos para alarme.
15 novembro 2023

Cinco das seis pessoas com ‘legionella’ no concelho de Caminha estão hospitalizadas, uma delas nos cuidados intensivos, e as autoridades continuam a investigar a origem da infeção, revelou hoje o delegado de saúde do Alto Minho.
14 novembro 2023